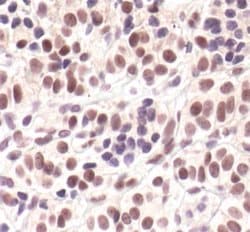
Invitrogen Phospho-Cyclin E (Thr62) Polyclonal Antibody 100 &mu;L | Buy Online | Invitrogen&trade; | Fisher Scientific

missing translation for 'onlineSavingsMsg'
Learn More
Learn More
Invitrogen™ Phospho-Cyclin E (Thr62) Polyclonal Antibody


Description
It is not recommended to aliquot this antibody.
Cyclin E belongs to the highly conserved cyclin family, whose members are characterized by a dramatic periodicity in protein abundance through the cell cycle. Cyclins function as regulators of CDK kinases. Different cyclins exhibit distinct expression and degradation patterns which contribute to the temporal coordination of each mitotic event. Cyclin E forms a complex with and functions as a regulatory subunit of CDK2, whose activity is required for cell cycle G1/S transition. This protein accumulates at the G1-S phase boundary and is degraded as cells progress through S phase. Overexpression of this gene has been observed in many tumors, which results in chromosome instability, and thus may contribute to tumorigenesis. This protein was found to associate with, and be involved in, the phosphorylation of NPAT protein (nuclear protein mapped to the ATM locus), which participates in cell-cycle regulated histone gene expression and plays a critical role in promoting cell-cycle progression in the absence of pRB. Two alternatively spliced transcript variants of this gene, which encode distinct isoforms, have been described. Two additional splice variants were reported but detailed nucleotide sequence information is not yet available.

Spécification
Spécification
| Antigène | Phospho-Cyclin E (Thr62) |
| Applications | Flow Cytometry, Immunohistochemistry (Paraffin), Immunoprecipitation, Western Blot |
| Classification | Polyclonal |
| Concentration | 83.4 μg/mL |
| Conjugué | Unconjugated |
| Formule | 0.01M HEPES with 100μg/mL BSA, 50% glycerol, 0.15M NaCl and no preservative; pH 7.5 |
| Expression | CCNE1 |
| Numéro d’ordre du gène | P24864 |
| Alias de gène | AW538188; Ccne; Ccne1; CycE1; CYCLE; cyclin E; cyclin E1; cyclin Es; cyclin Et; E-S; G1/S-specific cyclin-E1; pCCNE1 |
| Symboles de gène(s) | CCNE1 |
| Afficher plus |
Nom du produit
En cliquant sur Soumettre, vous reconnaissez que vous pouvez être contacté par Fisher Scientific au sujet des informations que vous avez fournies dans ce formulaire. Nous ne partagerons pas vos informations à d'autres fins. Toutes les informations de contact fournies seront également conservées conformément à notre politique de confidentialité. Politique de confidentialité.
Vous avez repéré une opportunité d'amélioration ?